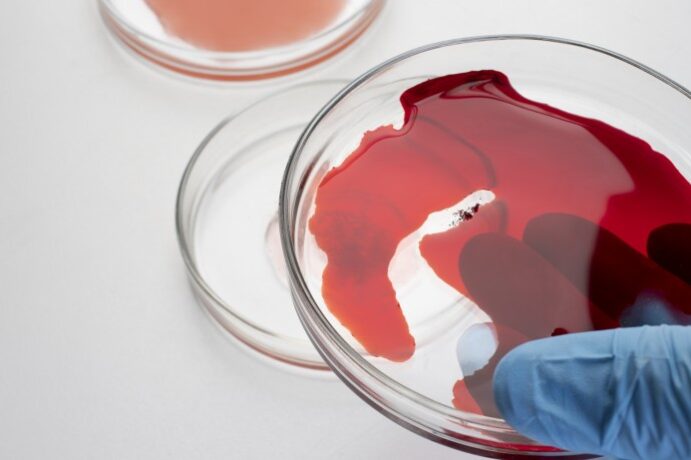

Загальний аналіз крові (автоматизований підрахунок на гематологічному аналізаторі, 25 показників, без ШОЕ)
250,00 грн.| Термін | Один день |
|---|
Загальний аналіз крові (ОАК) – це одне з найпоширеніших та інформативних лабораторних досліджень, що дозволяє оцінити загальний стан організму та роботу кровотворної системи. Аналіз допомагає виявити запальні та інфекційні процеси, анемію, порушення імунітету, проблеми зі згортанням крові та низку інших захворювань навіть на ранніх стадіях.
Лейкоцитарна формула – це розширений показник загального аналізу крові, який відображає співвідношення різних видів лейкоцитів. Вона показує не просто загальну кількість білих кров’яних клітин, а їх «розподіл» за типами, що дозволяє оцінити реакцію імунної системи на інфекцію, запалення, алергію чи інші патологічні процеси.
У клінічній практиці цей показник вважається більш інформативним, ніж просто рівень лейкоцитів, тому що зміни у формулі часто виникають раніше за виражені симптоми захворювання та допомагають лікарю швидше зорієнтуватися в причинах порушень.
Що таке лейкоцитарна формула крові
Лейкоцитарна формула – це відсоткове співвідношення різних типів лейкоцитів у крові. Кожен тип клітин виконує своє завдання, і саме їх баланс відображає стан імунної системи.
Основні функції аналізу формули:
- оцінка наявності запалення в організмі
- визначення типу інфекції (вірусна чи бактеріальна)
- виявлення алергічних реакцій
- контроль стану імунітету
Важливо розуміти, що лейкоцитарна формула не є самостійним діагнозом. Це діагностичний інструмент, який допомагає лікарю зрозуміти напрямок подальшого обстеження.
Види лейкоцитів та їх функції в організмі
Лейкоцити – це клітини імунної системи, які захищають організм від інфекцій, токсинів та пошкоджених власних клітин. Вони працюють як єдина система, але при цьому кожен тип виконує строго свою роль.
Основні групи лейкоцитів:
- нейтрофіли – швидко реагують на бактерії
- лімфоцити – забезпечують вірусну та імунну відповідь
- моноцити – «очищають» організм та беруть участь у відновленні
- еозинофіли – пов’язані з алергією та паразитами
- базофіли – беруть участь в алергічних та запальних реакціях
Ці клітини постійно взаємодіють між собою, формуючи повноцінну імунну відповідь організму.
Нейтрофіли: роль і норма в крові
Нейтрофіли – найчисленніша група лейкоцитів і перша лінія захисту при бактеріальних інфекціях. Вони першими «приходять» у вогнище запалення та починають знищення патогенних мікроорганізмів.
Їх основна функція – фагоцитоз, тобто поглинання та руйнування бактерій. Крім цього, вони беруть участь у формуванні запального процесу, який допомагає локалізувати інфекцію.
Підвищення нейтрофілів найчастіше пов’язане з:
- бактеріальними інфекціями
- гострими запаленнями
- стресом або фізичним навантаженням
- травмами тканин
Зниження нейтрофілів може вказувати на:
- пригнічення кісткового мозку
- вірусні інфекції
- дефіцит деяких речовин
- вплив ліків
Лімфоцити: функції та показники норми
Лімфоцити – ключові клітини адаптивного імунітету. Вони відповідають за розпізнавання «чужих» структур та формування специфічного захисту організму.
Їх робота більш «точкова» та тривала порівняно з нейтрофілами.
Основні типи лімфоцитів:
- T-лімфоцити – регулюють імунну відповідь та знищують інфіковані клітини
- B-лімфоцити – виробляють антитіла
- NK-клітини – знищують вірус-інфіковані та пухлинні клітини
Підвищення лімфоцитів частіше спостерігається при вірусних інфекціях, а зниження може бути пов’язане з:
- імунодефіцитними станами
- хронічним стресом
- важкими інфекціями
- прийомом деяких препаратів
Моноцити: за що відповідають і їх значення
Моноцити – великі клітини крові, які виконують функцію «санітарів» організму. Моноцити циркулюють у крові, а потім переходять у тканини, де перетворюються на макрофаги.
Їх основні завдання:
- видалення загиблих клітин
- знищення бактерій та чужорідних частинок
- участь у відновленні тканин
- регуляція запальних процесів
Підвищення моноцитів часто спостерігається:
- при хронічних інфекціях
- у період відновлення після хвороби
- при тривалих запальних процесах
Еозинофіли: роль в алергії та імунному захисті
Еозинофіли – клітини, які особливо активно беруть участь в алергічних реакціях та захисті від паразитів. Еозинофіли регулюють запалення та допомагають обмежувати пошкодження тканин при імунній відповіді.
Функції еозинофілів включають:
- участь в алергічних реакціях
- боротьбу з паразитарними інфекціями
- регуляцію запальних процесів
Підвищення еозинофілів частіше пов’язане з:
- алергією
- бронхіальною астмою
- паразитарними захворюваннями
- шкірними реакціями
Базофіли
Базофіли – найменш численна група лейкоцитів, але вони відіграють важливу роль у запуску алергічних реакцій. У їх гранулах містяться речовини, такі як гістамін, які беруть участь у розвитку запалення.
Хоча їх кількість у крові мінімальна, вони важливі для оцінки:
- алергічних станів
- хронічного запалення
- імунних реакцій
Зміни базофілів завжди оцінюються лише в комплексі з іншими показниками лейкоцитарної формули.
Норми лейкоцитарної формули у дорослих та дітей
Нормальні значення лейкоцитарної формули можуть незначно відрізнятися залежно від віку, стану організму та лабораторних референсів. Важливо розуміти, що оцінюється не лише абсолютна кількість лейкоцитів, але і їх відсоткове співвідношення.
У дорослих у середньому спостерігаються такі орієнтовні значення:
- нейтрофіли – 47–72%
- лімфоцити – 19–37%
- моноцити – 3–11%
- еозинофіли – 0,5–5%
- базофіли – 0–1%
У дітей показники можуть суттєво відрізнятися, особливо в ранньому віці. Наприклад, у немовлят та дошкільнят часто спостерігається фізіологічне переважання лімфоцитів, що вважається нормою.
Будь-які відхилення оцінюються лише в сукупності з клінічними симптомами та іншими аналізами.
Зміни лейкоцитарної формули: що це означає
Зрушення в лейкоцитарній формулі відображають реакцію організму на різні внутрішні та зовнішні фактори. Це може бути інфекція, запалення, стрес, алергія або більш серйозні порушення кровотворення.
Умовно зміни ділять на:
- зрушення вліво – збільшення молодих форм нейтрофілів, частіше при гострих бактеріальних інфекціях
- зрушення вправо – збільшення зрілих форм, може траплятися при деяких анеміях та хронічних станах
Також важливі ізольовані зміни окремих клітин, наприклад:
- зростання нейтрофілів → частіше бактеріальна інфекція
- зростання лімфоцитів → частіше вірусна інфекція
- зростання еозинофілів → алергія або паразити
Причини відхилень у лейкоцитарній формулі
Причини змін лейкоцитарної формули можуть бути як тимчасовими, так і пов’язаними із захворюваннями. Іноді це природна реакція організму, а іноді — сигнал про патологічний процес.
Часті причини змін:
- гострі та хронічні інфекції
- запальні захворювання
- алергічні реакції
- паразитарні інфекції
- стрес і фізичне перенапруження
- захворювання кісткового мозку
Важливо враховувати, що одне й те саме зрушення може мати різні причини, тому інтерпретація завжди проводиться лікарем.
Симптоми при змінах лейкоцитарної формули
Сам по собі аналіз не викликає симптомів, але зміни у формулі часто відображають процеси, які вже відбуваються в організмі. Клінічні прояви залежать від причини порушення.
Найчастіші симптоми:
- підвищена втомлюваність
- слабкість
- підвищення температури
- часті інфекції
- алергічні прояви
- збільшення лімфовузлів
Іноді зміни виявляються випадково при профілактичному обстеженні.
Діагностика: як оцінюється лейкоцитарна формула
Лейкоцитарна формула визначається в рамках загального аналізу крові за допомогою автоматичних аналізаторів або мікроскопічного підрахунку.
За необхідності лікар може призначити додаткові дослідження:
- розширений клінічний аналіз крові
- біохімічні показники
- маркери запалення (СРБ та ін.)
- імунологічні тести
У медичному центрі «Альтернатива» комплексна діагностика дозволяє оцінити не лише формулу, але й загальний стан організму.
Підготовка до аналізу крові на лейкоцитарну формулу
Щоб результати були максимально точними, важливо правильно підготуватися до здачі аналізу крові.
Рекомендується:
- здавати кров вранці натщесерце
- уникати інтенсивних фізичних навантажень за 24 години
- не вживати алкоголь
- за можливості знизити стресові навантаження
- узгодити прийом ліків з лікарем
Навіть незначні зовнішні фактори можуть вплинути на лейкоцитарну формулу.
Харчування та спосіб життя для нормалізації лейкоцитарної формули
Спосіб життя не впливає безпосередньо на формулу, але відіграє важливу роль у підтриманні нормальної роботи імунної системи.
Рекомендується:
- збалансоване харчування з достатньою кількістю білка та вітамінів
- регулярна помірна фізична активність
- повноцінний сон
- зниження рівня хронічного стресу
- відмова від шкідливих звичок
Такі заходи допомагають підтримувати стабільну роботу імунної системи.
Коли необхідно звернутися до лікаря
Звернутися до фахівця необхідно при виявленні значних відхилень у лейкоцитарній формулі, особливо якщо вони супроводжуються симптомами.
Приводом для консультації є:
- тривала слабкість і втомлюваність
- часті інфекції
- тривале підвищення температури
- виражені алергічні реакції
- збільшення лімфатичних вузлів
Рання діагностика дозволяє виявити причину змін та розпочати лікування на ранній стадії.
Профілактика порушень лейкоцитарної формули
Профілактика спрямована на підтримання нормальної роботи імунної системи та зниження ризику захворювань, що впливають на склад крові.
Основні заходи:
- регулярні профілактичні обстеження
- своєчасне лікування інфекцій
- контроль хронічних захворювань
- здоровий спосіб життя
- повноцінне харчування
У медичному центрі «Альтернатива» проводиться комплексна діагностика, що дозволяє виявляти зміни на ранніх стадіях та контролювати стан імунної системи.
Часті запитання про лейкоцитарну формулу
- Що показує лейкоцитарна формула? Вона відображає співвідношення різних видів лейкоцитів та допомагає оцінити стан імунної системи.
- Що означає підвищення нейтрофілів? Найчастіше пов’язане з бактеріальною інфекцією або гострим запаленням.
- Що означає підвищення лімфоцитів? Зазвичай спостерігається при вірусних інфекціях та імунних реакціях.
- Чому підвищуються моноцити? Часто при хронічних запаленнях або в період відновлення після хвороби.
- Що означає підвищення еозинофілів? Частіше пов’язане з алергією або паразитарними інфекціями.
- Чи небезпечні зміни лейкоцитарної формули? Самі по собі – ні, але вони можуть вказувати на захворювання, яке потребує діагностики.
- Чи можна поставити діагноз лише за лейкоцитарною формулою? Ні, вона оцінюється лише разом з іншими аналізами та симптомами.
- Чи може формула змінюватися тимчасово? Так, наприклад при стресі, інфекції або фізичному навантаженні.
Лейкоцитарна формула є важливим діагностичним інструментом, який відображає стан імунної системи та реакцію організму на різні патологічні процеси. Зміни у співвідношенні лейкоцитів допомагають лікарю визначити характер захворювання та обрати подальшу тактику обстеження.
Своєчасна діагностика, уважне ставлення до результатів аналізів та комплексний підхід до лікування дозволяють виявляти порушення на ранніх стадіях та запобігати розвитку ускладнень.
Загальний аналіз крові (автоматизований підрахунок на гематологічному аналізаторі, 25 показників, без ШОЕ)
250,00 грн.| Термін | Один день |
|---|
Загальний аналіз крові (ОАК) – це одне з найпоширеніших та інформативних лабораторних досліджень, що дозволяє оцінити загальний стан організму та роботу кровотворної системи. Аналіз допомагає виявити запальні та інфекційні процеси, анемію, порушення імунітету, проблеми зі згортанням крові та низку інших захворювань навіть на ранніх стадіях.